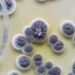

El conseller de Medio Ambiente, Infraestructuras y Territorio, Vicente Martínez Mus, ha destacado el compromiso del Consell con “la mejora y modernización de los sistemas de depuración y saneamiento de nuestros municipios con una inversión para este año cercana a los 50 millones de euros”.
Martínez Mus ha indicado que el objetivo “es dotar a nuestros vecinos de una seguridad hídrica, mejorar la calidad de las aguas y garantizar la salubridad de nuestros municipios y el medio ambiente con un programa de acción serio y riguroso”.
En este sentido, el conseller ha manifestado que, en dos años de legislatura, se han puesto en marcha dos planes anuales de infraestructuras de la Entidad Pública de Saneamiento de Aguas Residuales de la Comunitat Valenciana (EPSAR), al tiempo que ha criticado la “irresponsabilidad” del anterior Gobierno, que “no autorizó ni uno solo durante ocho años”.
De hecho, Martínez Mus ha explicado que en esta legislatura “hemos reactivado la EPSAR con la movilización de la mayor cantidad de recursos de su historia con una previsión de 50 millones de euros frente a los cinco millones de media de la anterior legislatura, multiplicando la inversión la dotación para cumplir con un servicio básico y esencial para los municipios”.
Este esfuerzo inversor, ha indicado, se está haciendo de forma paralela a la reconstrucción “en tiempo récord” de las 123 estaciones depuradoras que fueron dañadas por las riadas.
Martínez Mus ha puesto en valor alguna de las operaciones que se están ejecutando este año como la nueva Estación Depuradora de Aguas Residuales (EDAR) de Almoradí con un presupuesto de más de 19 millones de euros “que supone una inversión histórica para el municipio en una nueva instalación moderna, con tratamiento terciario y con mayor capacidad de depuración de agua”.
Además, ha resaltado otros proyectos como la renovación de la EDAR Algorós en Elche que para este ejercicio cuenta con un presupuesto de aproximadamente 5 millones de euros, las obras de conexión entre El Campello y con la EDAR Alicante Nord con 4 millones de euros, y actuaciones en Altea para renovar colectores por un millón de euros.
El titular de Infraestructuras ha subrayado que “el objetivo es continuar con este ritmo inversión” con proyectos como la nueva estación de bombeo de Mil Palmeras en Pilar de la Horadada que comenzarán en los próximos meses con una inversión de 2,5 millones de euros o la nueva estación depuradora de Burriana de la que ya se ha adjudicado la redacción del proyecto y que contará con un presupuesto de 35 millones de euros”.
Asimismo, ha destacado el papel de la Comunitat Valenciana como “referente nacional en gestión hídrica, con un reciclaje del 40 % del agua de toda España”, y ha reiterado el compromiso de la Generalitat de aumentar este porcentaje “hasta el 45 % al finalizar la legislatura con acciones centradas en la depuración”.
Un plan comprometido con los municipios
Martínez Mus ha señalado que “esta prioridad por mejorar y modernizar la red de saneamiento, colectores y depuradoras de la Comunitat Valenciana ya se inició en 2024 con un presupuesto de 30 millones y va a continuar en los próximos años con planes concretos realizados en colaboración con las diputaciones provinciales y los ayuntamientos”.
En este sentido, ha recordado los convenios firmados para ejecutar en los próximos cuatro años la modernización y mejora de sistemas de saneamiento con la Diputación de Castellón por un valor de 20,6 millones de euros para actuar en 80 municipios, y con la Diputación de Alicante, por 15,5 millones de euros en 27 localidades.
Asimismo, ha hecho referencia al acuerdo con el Ayuntamiento de Valencia para destinar cerca de 4,5 millones de euros en la limpieza de la parte final del tramo III del colector norte de la ciudad, y a la inversión de 14,5 millones de euros para modernizar las estaciones de bombeo (EBAR) y la estación depuradora (EDAR) en Benidorm.